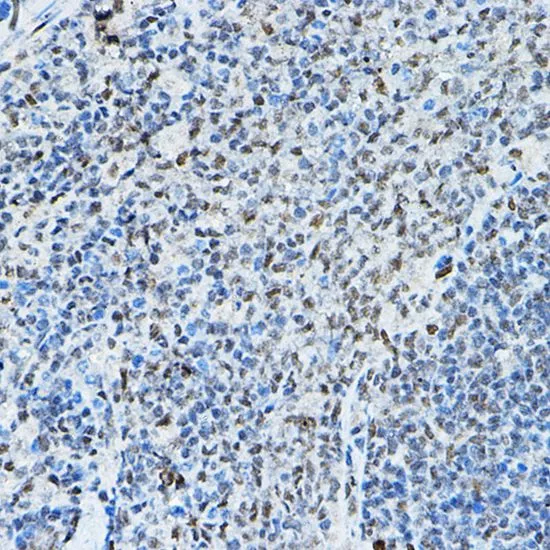

WB analysis of various sample lysates using GTX66517 SMRT antibody. Dilution : 1:1000 Loading : 25microg per lane
SMRT antibody
GTX66517
ApplicationsWestern Blot, ImmunoHistoChemistry, ImmunoHistoChemistry Paraffin
Product group Antibodies
TargetNCOR2
Overview
- SupplierGeneTex
- Product NameSMRT antibody
- Delivery Days Customer9
- Application Supplier NoteWB: 1:500 - 1:2000. IHC-P: 1:50 - 1:200. *Optimal dilutions/concentrations should be determined by the researcher.Not tested in other applications.
- ApplicationsWestern Blot, ImmunoHistoChemistry, ImmunoHistoChemistry Paraffin
- CertificationResearch Use Only
- ClonalityPolyclonal
- ConjugateUnconjugated
- Gene ID9612
- Target nameNCOR2
- Target descriptionnuclear receptor corepressor 2
- Target synonymsCTG26, N-CoR2, SMAP270, SMRT, SMRTE, SMRTE-tau, TNRC14, TRAC, TRAC-1, TRAC1, nuclear receptor corepressor 2, CTG repeat protein 26, T3 receptor-associating factor, silencing mediator for retinoid and thyroid hormone receptors, thyroid-, retinoic-acid-receptor-associated corepressor
- HostRabbit
- IsotypeIgG
- Protein IDQ9Y618
- Protein NameNuclear receptor corepressor 2
- Scientific DescriptionThis gene encodes a nuclear receptor co-repressor that mediates transcriptional silencing of certain target genes. The encoded protein is a member of a family of thyroid hormone- and retinoic acid receptor-associated co-repressors. This protein acts as part of a multisubunit complex which includes histone deacetylases to modify chromatin structure that prevents basal transcriptional activity of target genes. Aberrant expression of this gene is associated with certain cancers. Alternate splicing results in multiple transcript variants encoding different isoforms.[provided by RefSeq, Apr 2011]
- Storage Instruction-20°C or -80°C,2°C to 8°C
- UNSPSC12352203